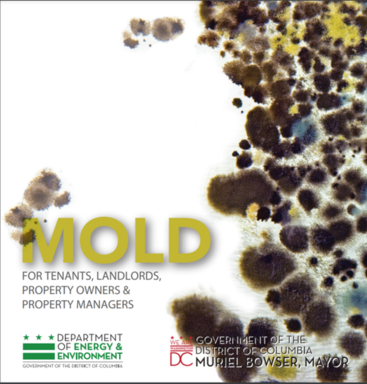
mold

|
DISTRICT AGENCIES WORKING TOGETHER TO PROMOTE HEALTHIER LIVING ENVIRONMENTS FOR DISTRICT RESIDENTS • Established by the Department of Energy and Environment (DOEE) and the Department of Health Care Finance (DHCF), the Interagency Working Group on Healthy Housing is made up of more than 15 government agencies with different missions, responsibilities, resources, and expertise but who all provide services to address poor housing conditions that impact the health and wellness of DC residents. The goal of the group is to enhance collaboration between agencies and provide a more coordinated approach to identifying and correcting harmful housing conditions and responding to residents’ concerns.
9 Steps to a Healthy Home
Deteriorated housing can put physical and mental health at risk. Asthma, lead poisoning, injuries, and viral infections are just some of the problems that are caused and/or exacerbated by poor housing conditions. Children are most vulnerable because they are still developing and in fact, living in poor housing conditions can lead to lifelong health, emotional, learning and behavioral challenges.
The Interagency Working Group on Healthy Housing created the Healthy Housing Directory to share simple ways for everyone to maintain a healthier home and also lists resources available to residents across agencies. The Directory provides the who, what, and how as well as links for more information on eligibility and how to apply. Currently, the Healthy Housing Directory is available online at the DC Partnership for Healthy Homes. The Directory will also soon be available on the Front Door website. Front Door is an interactive website that allows District residents to explore government resources that might be available to them including the resources included in the Healthy Housing Directory and others that will help current and/or future homeowners thrive in the District.
DOEE HELPS DISTRICT RESIDENTS AND LANDLORDS UNDERSTAND HOW TO PREVENT MOLD AND MOISTURE IN THEIR HOMES • Mold is a fungus that forms in the natural environment. Mold can grow wherever there is a water and food source, both indoors and outdoors. Some people have no reaction at all to mold. Some people may experience allergic reactions such as sneezing, eye irritations, or nose irritation. For those individuals with allergies and/or asthma, however, exposure to mold can cause health impacts including respiratory attacks. People who don’t already have an allergy to mold can develop one simply from exposure. To manage an indoor mold problem, the source of the water intrusion that is causing the mold to grow needs to be found and repaired. Otherwise, even if the mold is removed, it will return.
DOEE’s Mold Program helps District residents and property owners understand and remain compliant with the Air Quality Amendment Act of 2014 aka the DC Mold Act (the Act). The Act states that visible mold contamination greater than 10 square feet requires a DOEE licensed mold professional to assess and/or remediate. The mold professional must be licensed by DOEE’s Mold Program. Contamination less than 10 square feet can be addressed and removed by a non-licensed individual who must follow DOEE’s mold guidelines found in DOEE’s Guidance Document. Mold in caulking and grout in bathrooms and kitchens does not require services from a licensed DOEE mold professional.
The Act also specifies that Tenants must first notify the landlord or property owner in writing about mold issues in the home. The property owner must respond to the tenant within 7 days and clean and remove moldy conditions within 30 days. If the landlord fails to respond within seven days or repair the mold situation within 30 days, tenants can:
- Call DOEE’s Mold Program at 202 535-2600.
- Contact the District of Columbia Superior Court Housing Conditions Calendar at 202 879-1133 for assistance with filing a claim against the landlord (property owner). Only an attorney may file claims electronically.
- Choose a mold professional from the list of DOEE-Licensed Mold Professionals and pay for a mold assessor to evaluate the residence. If the tenant decides to bring a case to the Housing Conditions Court against the landlord, the judge may order the landlord/property owner to reimburse the tenant for the cost of the mold assessment.
To prevent mold from growing, indoor spaces should be kept dry and clean. To achieve this, you can:
- Use a dehumidifier in particularly humid areas such as basements;
- Increase indoor air circulation and ventilation ;
- Fix plumbing leaks as soon as possible;
- Clean and repair roof gutters regularly;
- Keep air conditioning drip pans clean and drain lines unobstructed and flowing properly;
- Protect vulnerable areas from flooding;
- Keep areas prone to humidity, like kitchens and bathrooms, well ventilated with fans and open windows;
- Ensure appliances that produce moisture, such as clothing dryers and stoves, vent water vapor to the outside;
- Insulate cold water pipes and other areas that may collect condensation.
For more information about mold, residents can also reference the EPA’s A Brief Guide to Mold, Moisture, and Your Home.
GARDENING SAFETY TIPS FROM DOEE’S OFFICE OF URBAN AGRICULTURE • Spring time is around the corner, and many District residents are eagerly planning their backyard gardens. Included in those plans should be ways to stay safe from harmful contaminants that can sometimes be found in soil. Lead, for example, can be absorbed by or settle on fruits or vegetables and can poison those who eat the food. As backyard gardening grows in popularity across the District, Kate Lee, Director of DOEE’s Office of Urban Agriculture has some advice for first-time gardeners: “For anyone venturing into gardening, a great first step is to test your soil. Soil tests are important for determining if you have risky heavy metals (like lead) in your soil, and for understanding what, if any, soil amendments are necessary to optimize crop growth.”
 Soil testing is an important way to avoid exposure to lead in soil. Soil tests are available at most land grant universities or through the local extension agency office. In the District, the University of the District of Columbia’s Environmental Quality Testing Laboratory offers soil testing.
What happens if the test results show your soil has contaminants? Soil tests often come with recommendations for amending your soil to limit the bioavailability of contaminants. The Office of Urban Agriculture recommends using organic amendments and closely following the instructions on any packages to minimize any potential environmental impacts. EPA’s Urban Gardening Fun Fact Sheet describes techniques commonly used to eliminate exposure to soil contaminants, including using raised soil beds, adding a thick layer of organic matter to the soil as physical barrier to contamination, and removing and replacing contaminated soil with clean soil tested and verified to be contaminant-free.
Visit the DOEE Office of Urban Agriculture’s webpage to learn about its work to increase food production in the District, or email Kate Lee at Kate.Lee@dc.gov. DOEE’s fact sheet on lead in the environment also has tips for reducing children’s outdoor exposure to lead.
ASTHMA FRIENDLY HOME CHECKLIST • Many common triggers of asthma and allergy symptoms originate in the home. The Asthma and Allergy Foundation of America has developed an Asthma-Friendly Home Checklist specifically to help people identify and reduce triggers in their home environment. The checklist provides a list of questions as well as information on the most common allergy and asthma triggers, and where they tend to be located. It also provides recommendations for how to fix the triggers or prevent exposure.
If there are questions about any of the triggers or ways to manage or fix them, residents should speak directly with their health care provider and/or asthma educator.
The Asthma and Allergy Foundation of America also offers a certification program for products that are deemed to contribute to a healthier home. The products are rigorously tested against strict standards. If they pass the test, they earn the CERTIFIED asthma & allergy friendly® designation. Go here for a list of more than 200 household products currently certified asthma & allergy friendly ranging from bedding to cleaning products to flooring to toys.
More information about asthma triggers can also be found at the Centers for Disease Control and Prevention (CDC) as well as the Environmental Protection Agency (EPA).
GEARING UP FOR ASTHMA AND ALLERGY AWARENESS MONTH • Each year, the Asthma and Allergy Foundation of America (AAFA) declares May to be Asthma and Allergy Awareness Month. In addition, World Asthma Day will be observed this year on May 4, 2022. Since May is peak allergy season, it’s the perfect time to educate about the prevalence and impact of these respiratory diseases, as well as the connection between housing conditions and respiratory illnesses.
Save the Date for the Annual Asthma & Allergy Network’s Asthma & Allergy Day Capitol Hill (AADCH) on May 3-4, 2022. The annual event offers discussions and webinars as well as opportunities to engage with members of Congress and advocate for people living with asthma and/or allergies. This year, the event will be both virtual and in-person and registration is expected to open in March. For more information, make sure to visit the Asthma & Allergy Network where you can also check out a recap of the 2021 virtual event.
Stay tuned for more information about local events in recognition of Asthma and Allergy Awareness Month hosted by DOEE in the next digest issue.
 NATIONAL PUBLIC HEALTH WEEK • The American Public Health Association has chosen April 4 – 10th, 2022 as National Public Health Week (NPHW). The 2022 NPHW theme is “Public Health is where you are”. Where we live impacts our health, and some communities have worse health outcomes because of where they live. Listening and learning from members of these communities is the first step to ensuring that public health is fair for all. Visit the NPHW website for more information, including toolkits and fact sheets.
|